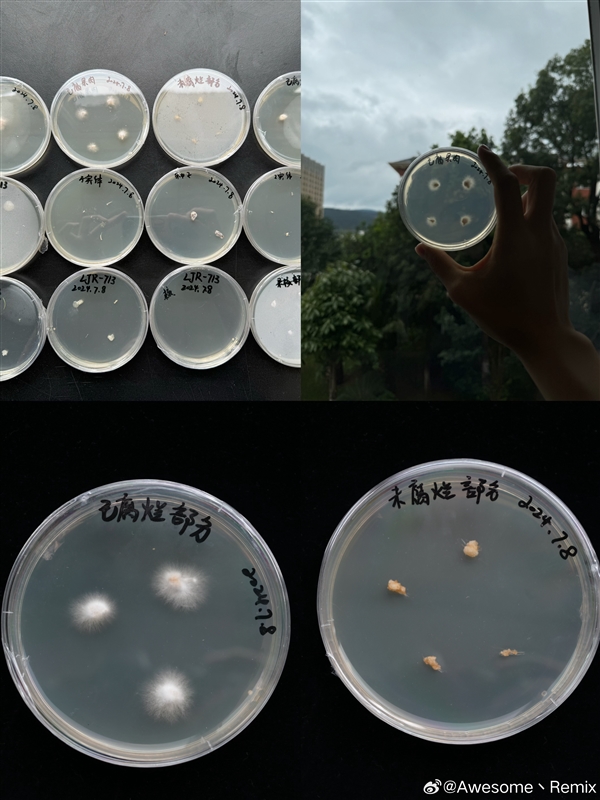

安然网7月12日消息,近日一位网友晒出家中出现一只长了“白色蘑菇”的苹果,在社交媒体上获得了数万点赞,结果被中科院在读博士许容聚私信求购,希望能做研究。
此事被曝光后引发大量关注,网友也将苹果寄给了许博士。

随后他通过微博汇报了最新的研究进展,通过提取白参子实体的DNA序列,现在成功鉴定到该菌株属于裂褶菌的模式种:Schizophyllum commune。
据介绍,这是一种裂褶菌,是在全球广泛分布的著名食用菌,一般长在腐木上,也作为植物病原菌存在,此前曾出现在桃子、柿子、椰子壳上。

许博士透露,之所以感兴趣是因为这是自己头一次在苹果上看到,尤其这一菌株靠很少的基质就长得如此强壮,可以为白参菌种的选育提供参考。
另外,如果是白参的菌丝侵染了苹果果肉或树木,那就有必要警惕白参可能对苹果种植产生的影响。

经过几天研究,许博士得出以下结论:
1.苹果未腐烂的部分是没有菌丝生长的,所以我们之前认为的白参已经入侵到新鲜菌丝中还有待进一步确认。
2. 苹果已腐烂部分菌丝生长的是最好的,所以可以初步推断,白参菌丝主要靠苹果已经腐烂的部分提供营养。
3.种子分离的培养皿有部分的细菌污染,属于正常现象。

– THE END –







评论0